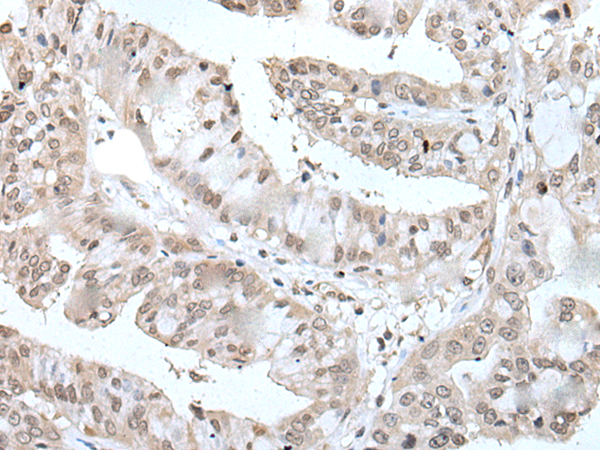
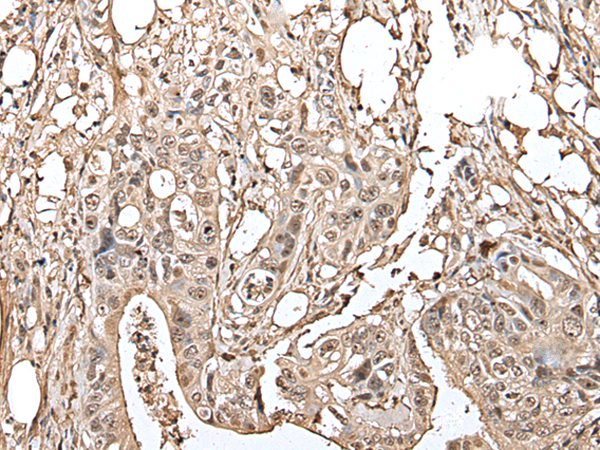
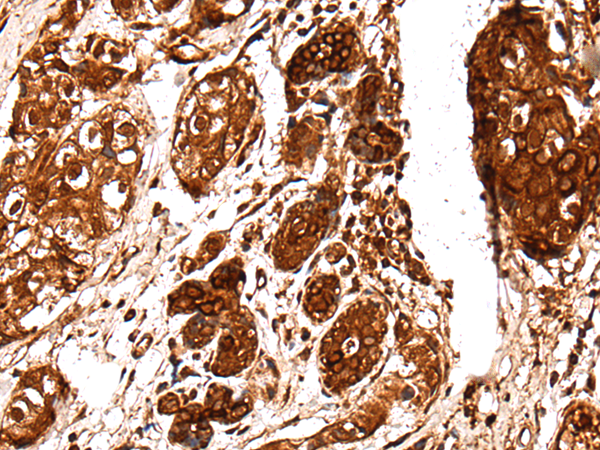
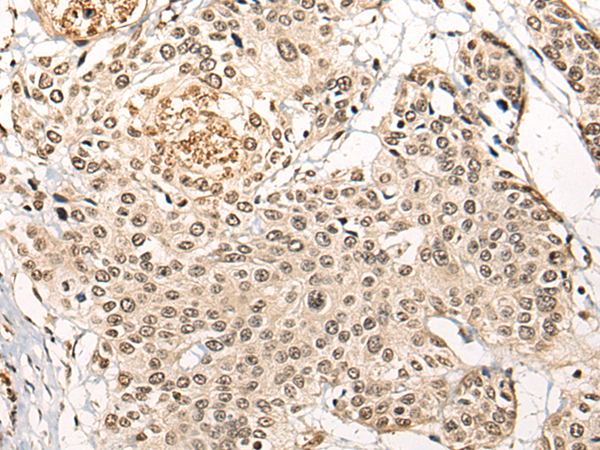
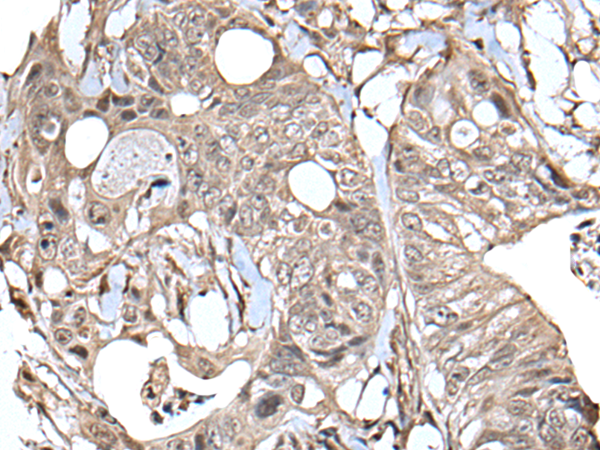
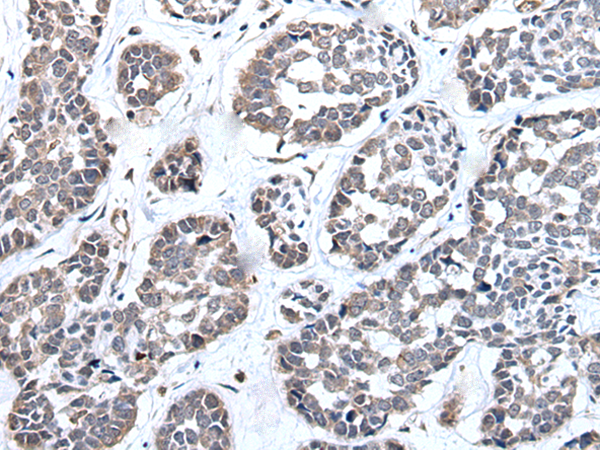

-
分类: 科研抗体货号: P09312别名: E4; UFD2; UBOX2应用: IHC反应种属: Human, Mouse, Rat
-
分类: 科研抗体货号: P09311别名: UBCH8应用: IHC反应种属: Human, Mouse
-
分类: 科研抗体货号: P09333别名: CRL1; CRLZ1; SAS10应用: IHC反应种属: Human, Mouse, Rat
-
分类: 科研抗体货号: P09309别名: SFT; UBCH5; UBC4/5; UBCH5A; E2(17)KB1应用: WB,IHC反应种属: Human, Mouse, Rat
-
分类: 科研抗体货号: P09351别名: BBH; BBOX; G-BBH; gamma-BBH应用: WB,IHC反应种属: Human, Mouse, Rat
-
分类: 科研抗体货号: P09332别名: CGI94; CGI-94; UTP11L应用: WB,IHC反应种属: Human, Mouse, Rat
-
分类: 科研抗体货号: P09308别名: MMS2; UEV2; EDPF1; UEV-2; DDVIT1; EDAF-1; EDPF-1; DDVit-1应用: WB,IHC反应种属: Human, Mouse, Rat
-
分类: 科研抗体货号: P09350别名: SFA2; B-ATF; BATF1; SFA-2应用: IHC反应种属: Human, Mouse, Rat
-
分类: 科研抗体货号: P09331别名: TGT应用: WB反应种属: Human, Mouse
-
分类: 科研抗体货号: P09306别名: UBCH9; UbcM2应用: WB,IHC反应种属: Human, Mouse

鄂公网安备42018502007531号
鄂公网安备42018502007531号

